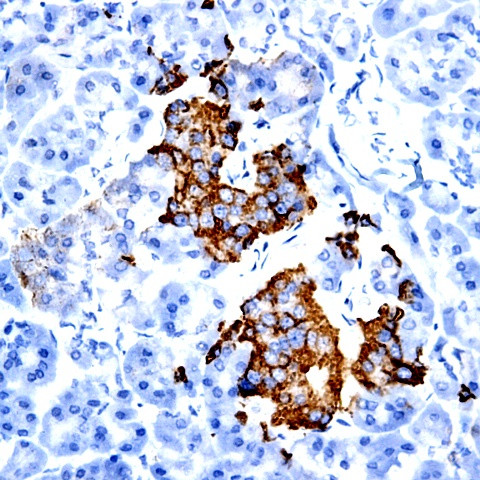
FGF 4 Antibody in Immunohistochemistry (Paraffin) (IHC (P))

Search
AbboMax
FGF 4 Polyclonal Antibody
{{$productOrderCtrl.translations['antibody.pdp.commerceCard.promotion.promotions']}}
{{$productOrderCtrl.translations['antibody.pdp.commerceCard.promotion.viewpromo']}}
{{$productOrderCtrl.translations['antibody.pdp.commerceCard.promotion.promocode']}}: {{promo.promoCode}} {{promo.promoTitle}} {{promo.promoDescription}}. {{$productOrderCtrl.translations['antibody.pdp.commerceCard.promotion.learnmore']}}
图: 1 / 2
FGF 4 Antibody (600-890) in IHC (P)


产品信息
600-890
种属反应
宿主/亚型
分类
类型
抗原
偶联物
形式
浓度
规格
纯化类型
保存液
内含物
保存条件
运输条件
产品详细信息
Positive control: Recombinant protein FGF-4
Cellular location: Secreted.
靶标信息
Fibroblast growth factor 4 (FGF4) is a member of the fibroblast growth factor (FGF) family that possess broad mitogenic and cell survival activities and play key roles in growth and survival of stem cells during embryogenesis, tissue regeneration, and carcinogenesis. FGF4 was identified by its strong oncogenic transforming activity and is a potent angiogenic factor, expressed in several highly vascularized tumors and also in adult mouse testis, intestine, and brain. Studies on the mouse homolog suggests a function in bone morphogenesis and limb development through the sonic hedgehog (SHH) signaling pathway. Furthermore, FGF4 regulates neural progenitor cell proliferation and neuronal differentiation. Recent studies show a growth-promoting role for FGF4 in human embryonic stem cells and a putative feedback inhibition mechanism by a novel FGF4 splice isoform that may serve to promote differentiation at a later stages of development.
仅用于科研。不用于诊断过程。未经明确授权不得转售。
篇参考文献 (0)
生物信息学
蛋白别名: FGF; FGF-4; FGF4si; Fibroblast growth factor; fibroblast growth factor (put.); putative; Fibroblast growth factor 4; HBGF-4; heparin secretory transforming protein 1; Heparin secretory-transforming protein 1; heparin-binding growth factor 1; Heparin-binding growth factor 4; HST; human stomach cancer, transforming factor from FGF-related oncogene; K-fibroblast growth factor; kaposi sarcoma oncogene; oncogene HST; Transforming protein KS3
基因别名: FGF-4; FGF4; Fgfk; HBGF-4; HST; HST-1; Hst1; HSTF-1; HSTF1; K-FGF; KFGF; KS3
UniProt ID: (Human) P08620, (Mouse) P11403
Entrez Gene ID: (Human) 2249, (Rat) 116499, (Mouse) 14175